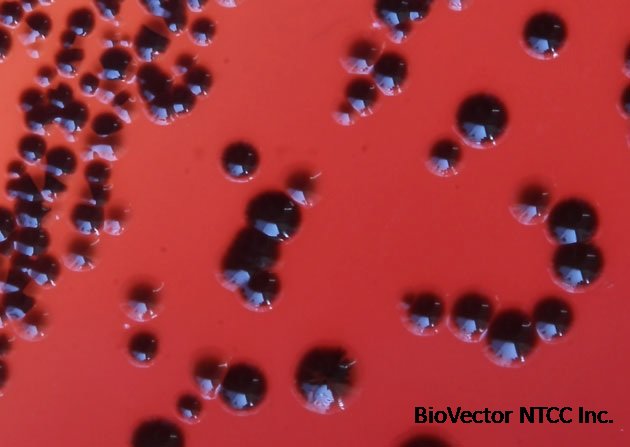

Porphyromonas gingivalis strain牙龈卟啉单胞菌菌株atcc 33277 BioVector NTCC质粒载体菌种细胞基因保藏中心
- 价 格:¥59865
- 货 号:Porphyromonas gingivalis 33277
- 产 地:北京
- BioVector NTCC典型培养物保藏中心
- 联系人:Dr.Xu, Biovector NTCC Inc.
电话:400-800-2947 工作微信:1843439339 (QQ同号)
邮件:Biovector@163.com
手机:18901268599
地址:北京
- 已注册
Porphyromonas gingivalis strain牙龈卟啉单胞菌菌株atcc 33277
Porphyromonas gingivalis (Coykendall et al.) Shah and Collins
BioVector-33277™
Type Strain. Strain is part of a set of quality control organisms for BioMerieux Vitek products.
Product category
Bacteria
Product type
Anaerobe
Strain designation
2561
Type strain
Yes
Genome sequenced strain
Yes
Isolation source
Gingival sulcus
Applications
Bioinformatics
Quality control
Product format
Freeze-dried
Storage conditions
2°C to 8°C
Specific applications
Quality control strain
Preceptrol
No
Characteristics
Comments
Invasion of gingival epithelial cells in culture
Genome sequenced strain
Component of MSA-1002, MSA-1003, and MSA-2002.
Handling information
Medium
BioVector Medium 2722: Supplemented Tryptic Soy Broth/Agar
Temperature
37°C
Atmosphere
Anaerobic
Handling procedure
Open vial according to enclosed instructions or visit www.atcc.org for instructions.
Under anaerobic conditions aseptically rehydrate the entire pellet with approximately 0.5 mL of #2722 broth. Aseptically transfer the entire contents to a 5-6 mL tube of #2722 broth. Additional test tubes can be inoculated by transferring 0.5 mL of the primary broth tube to these secondary broth tubes. Best practice dictates the use of pre-reduced media.
Use several drops of the primary broth tube to inoculate a Brucella blood plate and/or #2722 agar slant.
Incubate in an anaerobic atmosphere at 37°C for 48 to 72 hours. Incubate one agar plate aerobically at 37°C to check for contamination.
ANAEROBIC CONDITIONS:
Anaerobic conditions for transfer may be obtained by the use of an anaerobic gas chamber or placement of test tubes under a gassing cannula system connected to anaerobic gas.
Anaerobic conditions for incubation may be obtained by any of the following:
Loose screw caps on test tubes in an anaerobic chamber
Loose screw caps on test tubes in an activated anaerobic gas pack jar
Use of sterile butyl rubber stoppers on test tubes so that an anaerobic gas headspace is retained
Handling notes
Anaerobe Systems Brucella Blood plate (AS-111 or AS-141) can be use to analyze colony morphology and purity.
No growth occurs on sheep blood agar aerobically. A black pigment can be observed on Brucella Blood agar or Laked Blood agar after 5 days incubation.
Image:
Supplier来源:BioVector NTCC Inc.
TEL电话:400-800-2947
Website网址: http://www.biovector.net
- 公告/新闻




